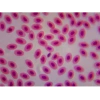
OMAX - 40X-2000X Dijital Binoküler LED Işık Mikroskobu MD827S30L

Siparişleriniz ve ürünler hakkında bilgi almak için bize Whatsapp Destek hattından ulaşabilirsiniz.
123.735,30 TL
114.217,20 TL
%8
9.518,10 TL 'den başlayan taksitlerle
ÜCRETSİZ KARGO
Havale/EFT ile 110.790,68 TL
- Ürün Kodu: B00684SH8O
- Marka: OMAX
- Kategori: Mikroskoplar
- Stok: 10
Hızlı Gönderi
GÜVENLİ ALIŞVERİŞ
- Toplam büyütme: 40X-80X-100X-200X-400X-800X-1000X-2000X; Okülerler: geniş alanlı WF10X/18 ve WF20X; Hedefler: akromatik DIN 4X, 10X, 40X(S), 100X(S, Yağ); Görüntüleme kafası: 45 derece eğimli 360 derece dönebilen dijital binoküler kafa; Gözbebekleri arası mesafe: sürgülü ayarlanabilir 5-7/40 cm ~ 5-38/40 cm (55mm ~ 75mm); Diyoptri: her iki göz merceği tüpünde de ayarlanabilir; Burunluk: döner dörtlü
- Aşama: mekanik leke tutmaz çift katmanlı boyut 12-2/5 cm x 12-2/5 cm(140 mm x 140 mm), çeviri aralığı: 7 cm x 5 cm (75 mm x 50 mm); Odak: her iki tarafta koaksiyel kaba ve ince odaklama düğmeleri, kremayer ve pinyon ayarı, gerginlik kontrollü; Odaklama düğmesi gözlem ve taşıma için kilitlenebilir; Kondenser ve diyafram: Abbe NA1. İris diyafram diyaframına sahip 25 kremayer ve pinyon ayarlı kondansatör
- Tabanda siyah avuç içi dayanağı; Aydınlatma: iletilen (alt), değiştirilebilir 3W LED ışık, değişken yoğunluk; Metal çerçeve; Güç kaynağı: AC 100V-240V 0. 2/0. 1A 50/60Hz dünya çapında aralık (ABD ve Kanada fişi)
- Dahili dijital kamera: - Görüntüleme cihazı: 3,0 mega piksel, 2/5. 12 cm CMOS - Etkin pikseller: 2048x1536 - Maksimum hareketsiz görüntü çözünürlüğü: 2048x1536 piksel - Kare hızı: 2048x1536'da saniyede 4 kare, 1024x768'de saniyede 10 kare - Arayüz: USB2. 0 ( 480MB/saniye) - SNR: >40dB - Windows XP/Vista/7/8/10 ve Mac OS ile uyumlu yazılım
GARANTİ
- Ürünlerimiz firmamız tarafından 2 yıl garantilidir.
TESLİMAT
- Ürün sipariş verildikten sonra en geç 7-11 günde tarafınıza kargolanmaktadır.
Benzer Ürünler
Hoşunuza Gidebilir
Yükleniyor...